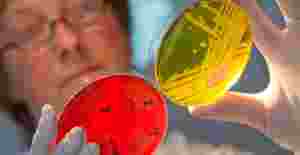

SLUČAJ PARAVINJA
U kamionu Dragana Paravinje pronađena krv Antonije... U kabni kamiona koji je vozio Dragan Paravinja, optužen za ubistvo maloljetne Antonije Bilić, pronađeni su tragovi krvi koja, kako piše zagrebački "Jutarnji list", pripada Antoniji Bilić.
U kamionu Dragana Paravinje pronađena krv Antonije... U kabni kamiona koji je vozio Dragan Paravinja, optužen za ubistvo maloljetne Antonije Bilić, pronađeni su tragovi krvi koja, kako piše zagrebački "Jutarnji list", pripada Antoniji Bilić.